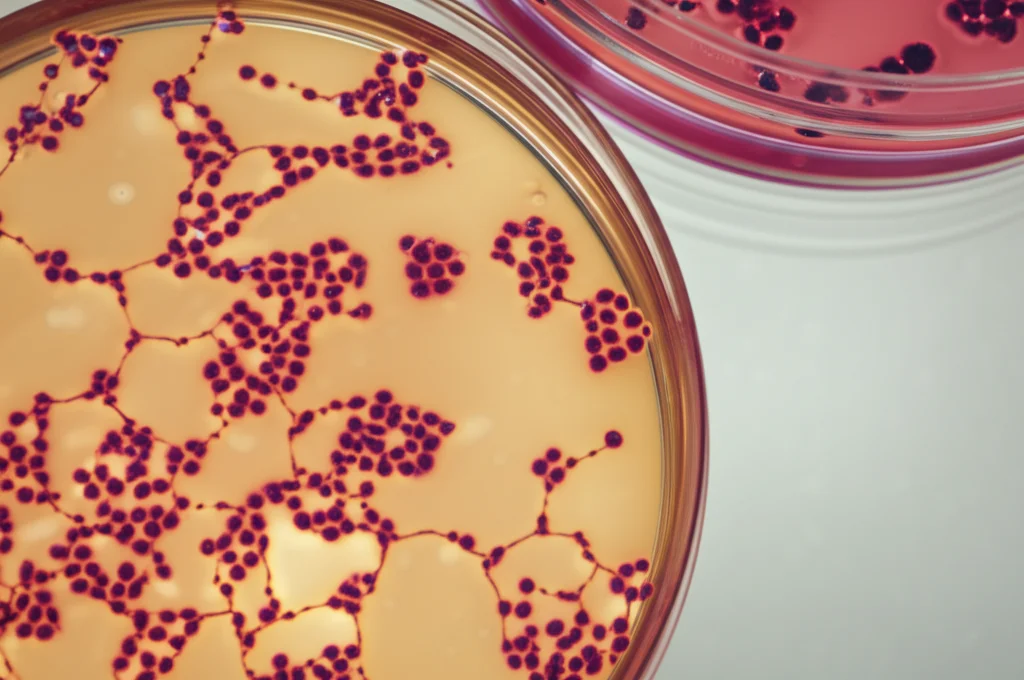
Microscopia di cellule staminali ematopoietiche in una piastra di Petri, illuminazione da laboratorio, obiettivo macro 60mm, dettagli cellulari visibili, sfondo leggermente sfocato.

Ruxolitinib e Trapianto nella Mielofibrosi: Stop Sicuro Senza Tempeste Infiammatorie?
Ciao a tutti! Oggi voglio parlarvi di un argomento che sta molto a cuore a chi combatte contro la mielofibrosi (MF), una battaglia complessa che coinvolge midollo osseo, milza e un sacco di molecole infiammatorie chiamate citochine. Immaginate il nostro corpo come un’orchestra finemente accordata; nella mielofibrosi, alcuni strumenti (le cellule del midollo) impazziscono a causa di mutazioni specifiche (come la famosa JAK2V617F), suonando una musica stonata e infiammatoria che porta a fibrosi nel midollo, ingrossamento della milza e sintomi che possono davvero peggiorare la qualità della vita.
Il Ruolo Chiave del Ruxolitinib
Per fortuna, abbiamo a disposizione farmaci intelligenti come il Ruxolitinib. Questo farmaco è un inibitore di JAK1/2, agisce come un direttore d’orchestra che cerca di calmare gli strumenti più scalmanati, riducendo le dimensioni della milza e alleviando i sintomi costituzionali. È un aiuto prezioso, non c’è dubbio. Ma, e c’è un “ma”, il Ruxolitinib non è una cura definitiva: non elimina la fibrosi midollare né il rischio che la malattia si trasformi in una leucemia acuta.
Il Trapianto: L’Unica Speranza di Cura (ma con Rischi)
L’unica strada per una guarigione completa, ad oggi, resta il trapianto allogenico di cellule staminali ematopoietiche (HSCT). È un percorso impegnativo, una sorta di “reset” completo del sistema immunitario e midollare. Tuttavia, come ogni procedura medica importante, ha i suoi rischi. Uno dei più temuti è la Graft-versus-Host Disease (GVHD), una reazione in cui le cellule trapiantate (il “graft”) attaccano i tessuti del ricevente (l'”host”). Inoltre, la mortalità non legata a recidiva (NRM) non è trascurabile, specialmente in pazienti già fragili a causa della mielofibrosi.
Il Dilemma: Cosa Fare con Ruxolitinib Prima del Trapianto?
Ed ecco il nodo cruciale che voglio sciogliere insieme a voi oggi. Dato che Ruxolitinib agisce sull’infiammazione e sul sistema immunitario, cosa succede se lo interrompiamo proprio prima di iniziare la preparazione al trapianto (il cosiddetto regime di condizionamento)? C’è il rischio di un “effetto rimbalzo”? Potrebbe scatenarsi una tempesta di citochine infiammatorie che peggiora la GVHD o causa altre complicazioni precoci? In passato, alcuni studi avevano sollevato questo dubbio, osservando eventi avversi come shock cardiogeno o sindrome da lisi tumorale in pazienti che avevano sospeso il farmaco. Ci siamo quindi chiesti: questa sospensione è davvero un problema? Aumenta il rischio?

Il Nostro Studio: Confronto tra Pazienti
Per capirci qualcosa di più, abbiamo condotto uno studio confrontando i profili delle citochine in diversi gruppi di pazienti con mielofibrosi in procinto di affrontare il trapianto:
- Un gruppo (chiamiamolo MF) che non aveva ricevuto Ruxolitinib prima del trapianto (18 pazienti).
- Un gruppo (MFR) che aveva ricevuto Ruxolitinib e lo aveva interrotto bruscamente il primo giorno del regime di condizionamento (53 pazienti).
- Un gruppo di controllo (OD) con altre malattie ematologiche (11 pazienti).
Abbiamo prelevato campioni di sangue in tre momenti chiave: prima del condizionamento (Baseline), intorno al giorno del trapianto (Giorno 0) e nella prima settimana post-trapianto (Settimana 1). In questi campioni, abbiamo misurato i livelli di ben 27 diverse citochine infiammatorie.
Cosa Abbiamo Osservato: I Risultati Chiave
Al Baseline (prima di tutto):
Come ci aspettavamo, i pazienti MF (senza Ruxolitinib) avevano livelli di citochine infiammatorie generalmente più alti rispetto ai controlli OD. Questo conferma lo stato pro-infiammatorio tipico della mielofibrosi. La citochina più significativamente aumentata era CD40, una molecola importante nell’attivazione immunitaria.
Confrontando invece i pazienti MFR (con Ruxolitinib interrotto) con i MF (senza Ruxolitinib), abbiamo visto chiaramente l’effetto del farmaco: i pazienti MFR avevano livelli significativamente più bassi di alcune citochine chiave come CD25, REG3A, IL18 e ST2. Queste sono tutte molecole note per essere coinvolte nell’infiammazione e, alcune, anche nella GVHD. Quindi, Ruxolitinib stava facendo il suo lavoro nel “calmare le acque” infiammatorie prima della sospensione.
Al Giorno 0 e alla Settimana 1 (dopo lo stop):
E qui arriva la parte più interessante! Cosa è successo dopo aver interrotto il Ruxolitinib nel gruppo MFR? C’è stato il temuto “rimbalzo” infiammatorio? La risposta è: apparentemente no.
Nei campioni prelevati al Giorno 0 e alla Settimana 1, le differenze significative nei livelli di citochine tra il gruppo MFR e il gruppo MF si sono largamente appianate. Non abbiamo osservato un aumento delle citochine nel gruppo MFR rispetto al gruppo MF. Anzi, per alcune citochine come IL18, i livelli tendevano a rimanere più bassi nel gruppo MFR anche subito dopo l’interruzione. In pratica, interrompere il Ruxolitinib all’inizio del condizionamento non sembrava scatenare quella tempesta infiammatoria che temevamo.

E il Rischio di GVHD?
Ok, niente tempesta di citochine evidente, ma questo si traduce in un minor rischio di GVHD? Abbiamo analizzato anche questo.
I livelli di citochine misurati al baseline (prima di tutto) non erano in grado di predire chi avrebbe sviluppato GVHD acuta (gradi 2-4) o iperacuta (molto precoce). Questo suggerisce che lo stato infiammatorio iniziale, pur diverso tra i gruppi, non era il fattore determinante per la GVHD successiva.
Invece, i livelli di alcune citochine misurati più tardi (specialmente alla Settimana 1, più vicino all’insorgenza della GVHD) erano effettivamente associati al rischio di sviluppare GVHD (ad esempio IL5, TNFR1, VEGF, ST2, TNFa, IL10, IL18 per la GVHD iperacuta). Tuttavia, questa associazione non era specifica per i pazienti che avevano interrotto il Ruxolitinib (MFR). Il loro profilo di rischio, basato sulle citochine post-trapianto, era simile a quello dei pazienti MF che non avevano mai preso il farmaco.
Un dato clinico interessante, sebbene non statisticamente significativo per via dei numeri ridotti, è che i pazienti MFR hanno avuto una tendenza ad avere meno GVHD iperacuta (28.3%) rispetto ai pazienti MF (50.0%). Questo va contro l’idea che interrompere Ruxolitinib aumenti il rischio.
Una Scoperta Inattesa: MMP-3
C’è stata anche una scoperta curiosa: i livelli di una molecola chiamata MMP-3 (Matrix Metalloproteinase-3) erano significativamente più alti nei pazienti MFR, specialmente al Giorno 0. La MMP-3 è coinvolta nel rimodellamento della matrice extracellulare e alcuni studi suggeriscono che livelli più bassi siano associati a maggior fibrosi midollare. Il fatto che Ruxolitinib sembri aumentare la MMP-3 potrebbe, ipoteticamente, avere un ruolo protettivo contro la progressione della fibrosi. È un’osservazione intrigante che merita ulteriori indagini.
Cosa Significa Tutto Questo? Tiriamo le Somme
Allora, cosa ci portiamo a casa da questo studio? Il messaggio principale è piuttosto rassicurante: interrompere il Ruxolitinib il primo giorno del regime di condizionamento prima del trapianto per mielofibrosi non sembra causare quel pericoloso rilascio di citochine infiammatorie che si temeva. I pazienti che seguono questa strategia non sembrano avere un profilo infiammatorio peggiore o un rischio di GVHD aumentato rispetto ai pazienti con mielofibrosi che non hanno mai assunto Ruxolitinib. Anzi, l’effetto “calmante” del farmaco su alcune citochine sembra persistere parzialmente anche nei primi giorni dopo la sospensione.
Certo, il nostro studio ha dei limiti, come il numero non altissimo di pazienti, che non ci permette di trarre conclusioni definitive sugli esiti clinici come l’incidenza esatta della GVHD. Tuttavia, i dati biologici sulle citochine sono abbastanza chiari.
La pratica di interrompere Ruxolitinib all’inizio del condizionamento sembra quindi ragionevolmente sicura dal punto di vista del “cytokine rebound”. La vera domanda ora è: potremmo ottenere benefici ancora maggiori continuando il Ruxolitinib più a lungo, magari fino al giorno stesso del trapianto o addirittura dopo? Alcuni studi stanno esplorando questa possibilità, ma servono dati più robusti.
Per ora, possiamo dire che quel timore specifico legato all’interruzione precoce sembra essere ridimensionato. Un piccolo passo avanti nella gestione sempre complessa del trapianto nella mielofibrosi!
Fonte: Springer
